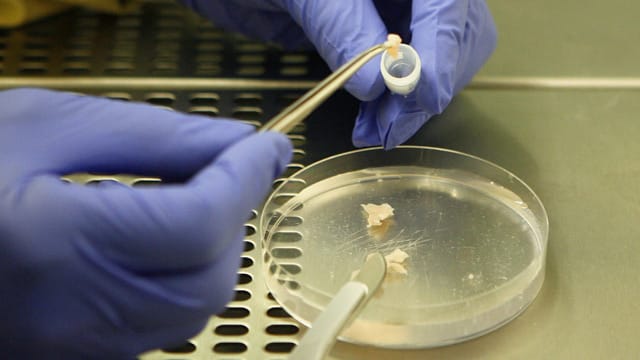

Schwangerschaft trotz Krebs Forscher: Einfrieren von Eierstock-Gewebe bei Krebs ist sicher
Junge Frauen, die an Krebs erkranken, haben zwar große Chancen auf Heilung, werden durch die Krebsbehandlung aber oft unfruchtbar. Eine Chance, später doch noch Kinder zu bekommen, ist das Einfrieren von Eierstockgewebe. Das Verfahren ist noch relativ neu, doch erste Studien sind vielversprechend.
Der Wunsch nach einem eigenen Kind kann zumindest für einige junge Frauen auch nach einer Krebsbehandlung noch in Erfüllung gehen. Bei einer Studie aus Dänemark sei die Entnahme von Eierstock-Gewebe vor der Therapie und eine anschließende Rückübertragung bei jeder dritten Frau erfolgreich gewesen. Das berichten Forscher der Universitätsklinik Kopenhagen im Fachblatt "Human Reproduction".
Keine Hinweise auf Krebs-Rückfall
Die Forscher um Annette Jensen hatten Daten von 41 dänischen Frauen ausgewertet, die entnommenes Eierstock-Gewebe im Alter von durchschnittlich 33 Jahren wieder eingesetzt bekamen. Die ursprüngliche Krebserkrankung kehrte bei diesen Patientinnen durch die Behandlung nicht zurück. Das hatten einige Experten befürchtet.
Schwangerschaft auf natürlichem Weg möglich
Von diesen Frauen wollten 32 schwanger werden. Zehn von ihnen bekamen mindestens ein Kind. Dazu zählten die Forscher auch eine Frau, die zum Studienzeitpunkt im dritten Drittel der Schwangerschaft war. Zusammengenommen kamen 14 Kinder zur Welt; entweder auf natürlichem Weg oder nach einer Kinderwunschbehandlung.
Die Chancen, eine Krebserkrankung in jungen Jahren zu überleben, seien in den vergangenen Jahrzehnten erheblich gestiegen, schreiben die Wissenschaftler um Jensen in ihrem Artikel. Allerdings kann eine Krebsbehandlung unfruchtbar machen. Deshalb werde der Erhalt der Fruchtbarkeit zunehmend zum Bestandteil moderner Krebstherapien. Bislang werden oft Eizellen eingefroren, deren Gewinnung allerdings zehn bis zwölf Tage Vorbehandlung benötigt.
Eierstock-Entnahme ist noch Neuland
Erst seit einigen Jahren entnehmen Ärzte, vor der Chemo- oder Strahlenbehandlung einen Eierstock oder Teile davon, frieren das Gewebe ein und pflanzen es später wieder in den Körper ein. Nach solch einer Behandlung sind weltweit nach Angaben der dänischen Forscher mehr als 36 Kinder geboren worden. Allerdings gab es zu den Erfolgsaussichten bisher noch wenig Erkenntnisse.
Bei einigen Frauen war das transplantierte Gewebe nach Angaben der Forscher schon seit rund zehn Jahren aktiv, bei anderen war es nach einigen Monaten nicht mehr funktionsfähig. Die Gründe für diese Unterschiede zwischen den Patientinnen sind bisher unbekannt. Bei drei der 41 Frauen, die ein Gewebe-Transplantat erhalten hatten, kam der Krebs danach zurück. Allerdings deute nichts darauf hin, dass es zwischen der Behandlung und dem Rückfall einen Zusammenhang gibt, schreiben die Forscher.
Einfrieren von Eizellen "sollte erste Wahl sein"
Der Erhalt der Fruchtbarkeit sei bei Krebstherapien von großer Bedeutung, weil inzwischen viele junge Frauen geheilt würden, sagte kürzlich Christian Thaler vom Vorstand der Deutschen Gesellschaft für Reproduktionsmedizin (DGRM). Die klassische Methode sei dabei aber nicht die Kryokonservierung von Eierstockgewebe, sondern von unbefruchteten Eizellen. "Das sollte immer die erste Wahl sein."
Erhalten Sie Antworten aus Tausenden t-online-Artikeln.
Antworten können Fehler enthalten und sind nicht redaktionell geprüft. Bitte keine personenbezogenen Daten eingeben. Mehr Informationen. Bei Nutzung akzeptieren Sie unsere Datenschutzhinweise sowie unsere t-online-Assistent Nutzungsbedingungen.
Das Einfrieren von Eizellen sei schon lange etabliert und entsprechend sicher, ergänzte Thaler, der das Hormon- und Kinderwunschzentrums am Klinikum der Ludwig Maximilians Universität München leitet. "Die Transplantation von Eierstockgewebe ist hingegen immer noch experimentell, und bisher sind erst einige wenige Kinder daraus hervorgegangen. Ich habe die Sorge, dass dieses Verfahren angesichts erfolgreicher Einzelfälle überbewertet wird."
- Die Informationen ersetzen keine ärztliche Beratung und dürfen daher nicht zur Selbsttherapie verwendet werden.